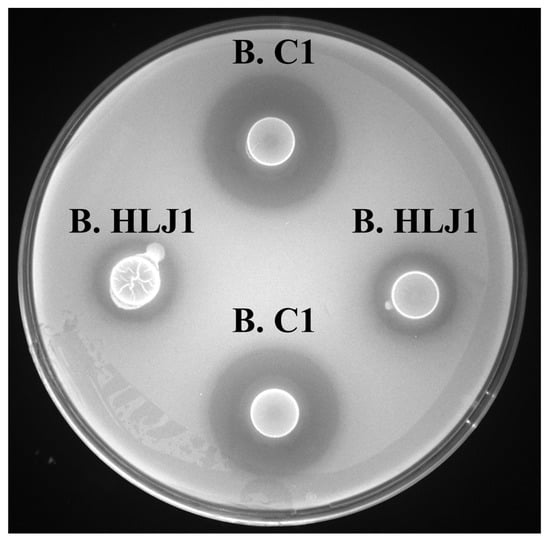

Abstract
The adoption of intensive farming has exacerbated disease outbreaks in aquaculture, particularly vibriosis caused by Vibrio parahaemolyticus. The use of probiotics to control V. parahaemolyticus is recognized as a good alternative to antibiotics for avoiding the development of antibiotic-resistant bacteria. In this study, two strains of B. HLJ1 and B. C1 with strong inhibitory activity on V. parahaemolyticus were isolated from aquaculture water and identified as Bacillus subtilis and Bacillus pumilus, respectively. Both B. HLJ1 and B. C1 lacked antibiotic resistance and virulence genes, suggesting that they are safe for use in aquaculture. In addition, these two strains can tolerate acid environments, produce spores, secrete extracellular enzymes, and co-aggregate as well as auto-aggregate with V. parahaemolyticus. B. HLJ1 and B. C1 produced the same anti-V. parahaemolyticus substance, which was identified as AI-77-F and belongs to amicoumacins. Both B. C1 and B. HLJ1 showed inhibitory activity against 11 different V. parahaemolyticus and could effectively control the growth of V. parahaemolyticus in simulated aquaculture wastewater when the concentration of B. C1 and B. HLJ1 reached 1 × 107 CFU/mL. This study shows that B. HLJ1 and B. C1 have great potential as aquaculture probiotics.
1. Introduction
Aquaculture has emerged as one of the sectors with the greatest growth rates due to its ability to supply high-quality animal protein [1]. However, the adoption of intensive farming to meet market demand has resulted in increased frequency of disease outbreaks in aquaculture, particularly vibriosis, which causes enormous economic losses every year [2]. Vibrio parahaemolyticus, one of the primary causative agents of vibriosis, can cause acute hepatopancreatic necrosis disease (AHPND) [3]. The global outbreaks of AHPND have led to a huge reduction in shrimp production, resulting in a tremendous loss of national income in the affected countries, such as China, Thailand, India, America, and so on [4]. For example, the AHPND outbreak in Thailand caused a drop in production from 611,194 t in 2011 to ca. 200,000 t by 2014/15, which caused consequential national losses of over USD 7.8–11 billion [5]. Traditionally, antibiotics have been used to prevent and treat vibriosis in aquaculture, but overuse of antibiotics has led to the development of antibiotic-resistant bacteria [6]. Alternatives to antibiotics have been researched in recent decades, and probiotics are considered to be environmentally friendly and promising alternatives [7].
In aquaculture, probiotics generally refer to live, dead, or bacterial cell components that can inhibit pathogens, promote nutrient absorption and improve immunity in aquaculture animals, and also purify the water quality of aquaculture water [8]. Most reported aquaculture probiotics belong to Lactobacillus and Bacillus owing to their wide distribution and adaptability, and some can produce antibacterial compounds [9]. It was found that shrimp feed containing 4 × 108 CFU/g of Lactobacillus plantarum SGLAB01 can reduce mortality when shrimps were infected by V. parahaemolyticus [10]. When L. plantarum ATCC 8014 was added at a concentration of 1 × 107 CFU/mL, the number of V. parahaemolyticus and the mortality of pacific oysters dramatically decreased [11]. B. subtilis AQAHBS001, isolated from the intestine of pacific white shrimp in Thailand, can inhibit the growth of V. parahaemolyticus, and 1 × 107 or 1 × 109 CFU/kg in the feed can significantly improve the resistance of shrimp to V. parahaemolyticus [12]. The addition of 1 × 108 CFU/g of B. coagulans ATCC 7050 in feed can enhance the growth of Litopenaeus vannamei and also resistance to V. parahaemolyticus [13]. B. licheniformis ATCC 11946 at 108 CFU/g in feed can increase the survival rate of pacific white shrimp which was infected with V. parahaemolyticus [14]. Supplementing the diet of white shrimp with 1 × 108 CFU/g of B. subtilis WB60 reduces mortality in shrimp infected with V. parahaemolyticus [15].
A good probiotic must be safe for aquatic organisms in aquaculture, which can directly inhibit pathogenic bacteria or indirectly improve the resistance of aquatic organisms to diseases by purifying water quality and improving the nutrient absorption and immunity of aquatic organisms [1]. So, probiotics used in aquaculture are usually tested for their inhibitory activity against pathogens, tolerance to acid and high temperatures, and safety [16,17]. In addition, the capacity to secrete extracellular enzymes, to auto-aggregate, and to co-aggregate with pathogens are also criteria to assess probiotics in aquaculture [18].
In this study, almost 200 strains were isolated from aquaculture water samples, and a total of 12 strains with inhibitory activity against V. parahaemolyticus were selected using the double-layer plate method. Then, selected strains were co-cultured with genetically modified V. parahaemolyticus, which constitutively expressed GFP as an indicator for evaluating inhibitory effect in a liquid environment. Subsequently, the potential probiotics were identified by 16S rDNA amplification and safety, and other probiotic properties were also evaluated. Furthermore, the anti-V. parahaemolyticus substances produced by the potential probiotics were extracted, purified, and identified. Finally, the inhibitory activity of potential probiotics against 11 different V. parahaemolyticus was tested, as well as the inhibitory effect on V. parahaemolyticus in simulated aquaculture water.
2. Materials and Methods
2.1. Sample Collection and Bacteria Isolation
Aquaculture water samples were obtained from Foshan, Guangdong Province, China. The water samples were treated at 80 °C for 20 min; water samples with high-temperature treatment and original water samples were sequentially diluted with sterile PBS in a gradient manner (10−1, 10−2 and 10−3). Then, 100 μL of serial dilutions were spread on Luria–Bertani (LB) agar plates and DeMan–Rogosa–Sharpe (MRS) agar plates. All agar plates were incubated at 37 °C for 24 h. The purified single colony was inoculated into 10 mL LB liquid medium and cultured at 37 °C for 16 h. The bacterial solution was mixed with 60% glycerin by volume of 2:1 in a cryopreserved tube and stored at −80 °C.
2.2. Screening of Anti-V. parahaemolyticus Bacteria
2.2.1. Primary Screening for Strains by Double-Layer Plate Method
The Vibrio strain used for the primary screening was V. parahaemolyticus ATCC17802, which carries the trh virulence genes. The trh are the main virulence factors responsible for cardiotoxicity, enterotoxicity, and erythrocyte hemolysis [19,20]. The inhibitory activity against V. parahaemolyticus of the isolated strains was tested using a double-layer plate method as previously described [21], with minor modifications. First, 10 mL of LB agar was spread on the bottom of the plate, and then 10 mL of LB agar containing 107 CFU/mL of V. parahaemolyticus was spread on top. Afterwards, 8 mm wells were punched out in the top agar layer using an Oxford cup, and 100 μL of the isolated strains were added to the wells. After incubation at 37 °C for 24 h, the diameter of the inhibition circle was measured.
2.2.2. Second Screening for Strains by Co-Culture Method
To facilitate the measurement of V. parahaemolyticus growth in the mixed culture system, V. parahaemolyticus ATCC17802 harboring puC19-GFP plasmid with a GFP overexpression (named as 17802 [GFP]) was obtained by genetic engineering. The 17802 [GFP] was co-cultured with isolated strains in 96 microwell plates (final volume: 200 μL) as Goulden et al. described [22]. The 17802 [GFP] was set at a concentration of 104 CFU/mL and the final concentration of isolated strains was at 105, 106, and 107 CFU/mL, respectively.
Using the LINEST function in Excel, the relationship between fluorescence and the number (lg CFU/mL) of 17802 [GFP] was examined, and there was a multiplicative power relation between fluorescence and the 17802 [GFP] number at the first 12 h (y = 6.6895x0.0593; R² = 0.9835). Based on the fluorescence signal and the relationship between fluorescence and the growth of V. parahaemolyticus, the number of V. parahaemolyticus in the experimental group (N1) and the number of V. parahaemolyticus in the control (N0) were calculated and the inhibition rate of V. parahaemolyticus was calculated as follows:
The inhibitory effect of strains on V. parahaemolyticus was classified into three categories: low inhibitory activity (25% ≤ Inhibition rate of V. parahaemolyticus < 50%), moderate inhibitory activity (50% ≤ Inhibition rate of V. parahaemolyticus < 75%), and high inhibitory activity (Inhibition rate of V. parahaemolyticus ≥ 75%).
2.3. Identification of Strains
The DNA of the isolated strains was extracted according to the manufacturer’s instructions by using the Bacteria DNA Isolation Mini Kit (Vazyme, Nanjing, China). The 16S rDNA gene was amplified by a polymerase chain reaction (PCR) using primers 27F (AGAGTTTGATCMTGGCTCAG) and 1492R (GGTTACCTTGTTACGACTT). Many Bacillus species have been observed to display fairly conserved 16S rRNA sequences compared to other genera, and the use of this taxonomic marker is sometimes insufficient to define the species [23]. For this reason, the analysis of additional housekeeping genes, such as gyrA, gyrB, and pycA, has been recently incorporated in order to obtain a more reliable phylogeny [24,25,26,27]. We additionally used the gyrB and pycA genes for the identification of Bacillus strains. Partial sequences of gyrB and pycA were amplified using specific primers [28,29]. The pure DNA products were delivered to Sangon Biotech Co., Ltd. (Shanghai, China) for sequencing. The nucleotide sequences were subsequently compared with the available sequences in the database of the National Center for Biotechnology Information (NCBI) using the Basic Local Alignment Search Tool (BLAST) program (https://blast.ncbi.nlm.nih.gov/Blast.cgi, accessed on 15 June 2022). Multiple sequence alignments were obtained by using the CLUSTALW software included in the MEGA-X software package. The phylogenetic tree of isolated strains was constructed based on the comparison of other bacterial sequences using neighbor-joining (NJ) analysis with 1000 bootstrap replicates.
2.4. Safety of the Candidate Strains
2.4.1. Antibiotic Susceptibility
The antibiotic susceptibility of the isolated strains was determined using the Clinical and Laboratory Standard Institute’s (CLSI) broth microdilution method. The antibiotics recommended by the European Food Safety Authority Panel on Additives and Products or Substances Used in Animal Feed (FEEDAP 2012) include teicoplanin, vancomycin, chloramphenicol, tetracycline, erythromycin, gentamycin, and kanamycin. According to the guidelines of CLSI, the isolated strains were classified as sensitive, intermediate, or resistant.
2.4.2. Virulence Factor Genes
The enterotoxin genes nheA, nheB, nheC, hblA, hblC, hblD, and entFM were identified by PCR while double-distilled water was used as a negative control. The sequences of all primers used were designed according to the previous study [30]. The PCR results were examined using agarose gel electrophoresis (1% w/v) and gels were imaged under UV light after electrophoresis.
2.5. Acid Tolerance and Spore Production of the Candidate Strains
2.5.1. Acid Tolerance Assay
The acid tolerance of the strains was measured as previously described [31]. The strains were incubated in LB medium at 37 °C for 2 h at pH 3–7 (pH 7 was used as a control). The survival rate was calculated by the plate count method.
2.5.2. Spore Production Assay
After the strains were incubated at 37 °C for 24, 36, 48, 60, 72, and 96 h, the cultures were diluted at 10−4, 10−5, and 10−6, and then treated at 80 °C for 20 min. The number of survival bacteria in the experimental group (N1) and the number of bacteria in the control (N0) were calculated using the plate count method:
2.6. Extracellular Enzyme Activity and Aggregation Capacity
2.6.1. Extracellular Enzyme Activity
The extracellular enzyme activity of the strains was evaluated qualitatively using starch agar, CMC-Na agar, and skim milk agar, as described by Zhou et al. [32]. The presence of a halo or clear zone indicated a positive result.
2.6.2. Auto-Aggregation and Co-Aggregation Assay
Auto-aggregation and co-aggregation assays were described by Mustafa et al. [33]. The isolated strains were incubated in LB medium for 24 h at 37 °C and centrifuged at 5000 rpm for 10 min. The pellet was washed twice in phosphate-buffered saline (PBS) and then adjusted to a cell concentration of 108 CFU/mL. The auto-aggregation rate was calculated as follows:
A0 = Absorbance at 0 h (OD 600 nm)
A1 = Absorbance at 2 h, 24 h (OD 600 nm)
The isolated strains and V. parahaemolyticus were mixed for 10 s in a 15 mL conical tube, followed by incubation at 37 °C for 2 and 24 h. The co-aggregation rate was calculated as follows:
Amix = Absorbance at 2 h, 24 h (OD 600 nm)
Aisolate = Absorbance of isolated bacteria at 0 h (OD 600 nm)
Apathogen = Absorbance of pathogenic bacteria at 0 h (OD 600 nm)
2.7. Identification of Anti-V. parahaemolyticus Substance
A three-step procedure was applied to purify and identify the anti-V. parahaemolyticus substance, including: (i) The 2 L supernatant was extracted three times with an equal volume of ethyl acetate and then extracts were concentrated by rotary evaporation at 30 °C under reduced pressure. The above-mentioned dried ethyl acetate extract was re-dissolved in 5 mL methanol and the solvent was filtered through a 0.22 μm nylon membrane. (ii) The crude extracts were chromatographed on Sephadex LH-20 (16 mm × 70 mm), eluting with methanol at a flow rate of 2 mL/min. A total of 280 mL of eluate was collected (14 mL per tube), and the obtained eluate from each tube was tested for inhibitory activity against V. parahaemolyticus. The active fractions were combined and then injected into a C18 column (Agilent ZORBAX 300SB-C18, 4.6 × 150 mm, 5-Micron, 1 mL/min). The mobile phase consists of 0.1% trifluoroacetic acid (TFA)-water (solvent A) and 0.1% TFA-acetonitrile (solvent B). The gradient elution procedure was as follows: from 0 to 20.0 min with 5 to 80% solvent B, from 20.0 to 21.5 min with 80% to 100% solvent B, from 21.5 to 27.0 min with 100% solvent B, from 27.0 to 27.5 min with 100% to 5% solvent B, and from 27.5 to 30 min with 5% solvent B. The active peaks, where the anti-V. parahaemolyticus substances were located, were identified. (iii) The active compounds were analyzed by LC-MS (Thermo Scientific™ Accucore™ aQ C18-LC coupled with Thermo Scientific Q-Exactive ESI-MS, Waltham, MA, USA). The MS analysis uses a scan range of 50–750 (m/z) with an accuracy of 0.002% for ± mass determination.
2.8. Inhibitory Activity against Different V. parahaemolyticus
The inhibitory activity of two strains against 11 different V. parahaemolyticus was tested by the double-layer plate method. After incubation at 37 °C for 24 h, the diameter of the inhibition zone was measured.
2.9. Anti-V. parahaemolyticus Effect in Simulated Aquaculture Wastewater
The two strains were co-cultured with V. parahaemolyticus 17802 in simulated aquaculture wastewater, respectively. According to a previous report by Zhang et al. [34], synthetic wastewater media (SWM) were used to simulate aquaculture wastewater. V. parahaemolyticus was inoculated into 100 mL SWM at approximately 104 CFU/mL, while two strains were inoculated at 105, 106, and 107 CFU/mL, respectively. The number of V. parahaemolyticus was measured using thiosulfate citrate bile salts sucrose agar plates (TCBS).
3. Results
3.1. Screening of Anti-V. parahaemolyticus Bacteria
3.1.1. Primary Screening by Double-Layer Plate Method
As described in the material and methods section, almost 200 strains were isolated from aquaculture water sample and inhibitory activities against V. parahaemolyticus were assessed. Inhibitory activity was judged by the formation of inhibition circles on the plate and the results are shown in Table 1. A total of 12 strains showed obviously inhibitory activity against V. parahaemolyticus. Among those strains, B. C1 showed the strongest inhibitory effect, producing an inhibitory circle of more than 20 mm. The practical application of the strains in aquaculture is in a liquid environment, so the 12 strains with V. parahaemolyticus inhibitory activity in Table 1 were selected for the second screening experiment and co-cultured with V. parahaemolyticus in liquid medium.

Table 1.
Inhibitory activity of selected bacteria against V. parahaemolyticus.
3.1.2. Second Screening for Strains by Co-Culture Method
Both 17802 [GFP] and wild type V. parahaemolyticus ATCC 17802 have identical growth profiles. The isolated strains were co-cultured with 17802 [GFP] at 105, 106, and 107 CFU/mL, respectively. When the initial concentration of isolated strains was set at 1 × 105 CFU/mL, the strains had relatively low inhibitory activity against V. parahaemolyticus and the inhibition rates were less than 25%—except for strain JZ12 which showed low inhibitory activity against the growth of V. parahaemolyticus with the inhibition rate against V. parahaemolyticus at 40.88%. The strain JZ12 shows moderate inhibitory activity against the growth of V. parahaemolyticus and the inhibition rate of JZ12 against V. parahaemolyticus was 51.29% when the initial concentration of isolated strains increased to 1 × 106 CFU/mL. In this initial concentration (1 × 106 CFU/mL), the inhibition rates of two strains (B. C1, B. HLJ1) against V. parahaemolyticus were 32.61% and 37.88%. At the highest initial concentration (1 × 107 CFU/mL), strains JZ12 and M. JZ5 showed moderate inhibitory activity against V. parahaemolyticus and the inhibition rates of V. parahaemolyticus were 61.41% and 74.67%, respectively. The strains B. C1, B. HLJ1, M. CY1, M. SY7, and M. HLJ3 showed high inhibitory activity against the growth of V. parahaemolyticus, the inhibition rates of the five strains against V. parahaemolyticus were 100%, 100%, 100%, 100%, and 95.04%, respectively. (Figure 1). Similar to the studies reported, the antagonistic activity of the candidate strains against V. parahaemolyticus in planktonic and attached forms might be different [22].

Figure 1.
Assessment of inhibitory effect of isolated strains on V. parahaemolyticus. The concentration of V. parahaemolyticus was 1 × 104 CFU/mL and the concentrations of isolated strains were 1 × 107 CFU/mL (Yellow), 1 × 106 CFU/mL (Purple), and 1 × 105 CFU/mL (Pink), respectively.
Based on the above experimental results, strains B. C1, B. HLJ1, M. CY1, M. SY7, and M. HLJ3 with high inhibitory activity against V. parahaemolyticus were selected for the following experiments.
3.2. Identification of Strains
The 16S rDNA sequences of B. C1, B. HLJ1, M. C1, M. SY7, and M. HLJ3 were compared by BLAST search in NCBI, and a phylogenetic tree was constructed by the NJ method in the MEGA-X software package. The results showed that M. C1 and Lactococcus garvieae (NR104722.1) clustered into the same branch, and M. SY7 clustered with L. garvieae (NR113268.1), so the M. C1 and M. SY7 were identified as L. garvieae. The M. HLJ3 and Enterococcus faecalis (NR115765.1) clustered into the same branch and M. HLJ3 could be identified as E. faecalis. Both L. garvieae and E. faecalis are conditional pathogenic bacteria that cannot be used as aquaculture probiotics. B. C1 and B. HLJ1 could be identified as Bacillus by 16S rRNA, and the phylogenetic tree constructed based on the gyrB gene could reveal that B. C1 clustered with B. pumilus GBSW2 (GU568234.1) (Figure 2A) and B. HLJ1 clustered with B. subtilis Y98b (JX513934.1) (Figure 2B). The phylogenetic tree constructed based on the pycA gene showed similar results, with B. C1 clustering with B. pumilus 3–19 (CP054310) (Figure 2C) and B. HLJ1 clustering with B. subtilis NRS6167 (OX419562.1) (Figure 2D). Therefore, B. C1 was identified as B. pumilus and B. HLJ1 was identified as B. subtilis. B. HLJ1 and B. C1 were selected as candidate probiotics for the following experiments. The partial 16S rDNA sequences of B. C1 and B. HLJ1 were submitted to GenBank, and the accession numbers were assigned as OQ518912 and OQ519649.

Figure 2.
Phylogenetic tree of B. C1 and B. HLJ1 using NJ method. (A) B. C1 based on gyrB gene, (B) B. HLJ1 based on gyrB gene, (C) B. C1 based on pycA gene, and (D) B. HLJ1 based on pycA gene.
3.3. Safety of the Candidate Strains
The safety of probiotics is very important for aquaculture; therefore, safety tests including antibiotic resistance and virulence genes need to be conducted on candidate probiotics before application. Antibiotic resistance genes can be transferred between bacteria, leading to the development of antibiotic-resistant bacteria [33]. Thus, antibiotic resistance of probiotic bacteria is a key factor for application in aquaculture. Bernhard et al. [35] demonstrated the transfer of the tetracycline resistance gene from B. cereus to B. subtilis, the plasmid carrying resistance to tetracycline, pBC16, which was originally isolated from B. cereus, could be subsequently transformed in B. subtilis and stably maintained. The minimum inhibitory concentration (MIC) of antibiotics against B. C1 and B. HLJ1 were measured using the broth microdilution method, and the susceptibility of the strains to the corresponding antibiotics was assessed using the CLSI guidelines. B. C1 and B. HLJ1 were sensitive to most of antibiotics required by EFSA (FEEDAP 2012), but B. C1 showed intermediate sensitivity to erythromycin and B. HLJ1 showed intermediate sensitivity to chloramphenicol (Table 2). The experimental results indicate that B. C1 and B. HLJ1 have fewer antibiotic resistance factors.

Table 2.
Antibiotic resistance of B. C1 and B. HLJ1.
Virulence genes in probiotics is critical because expression of virulence genes can lead to disease outbreaks in aquaculture animals and virulence genes possibly transferred from probiotics to other bacteria [30]. In this study, enterotoxin genes nheA, nheB, nheC, hblA, hblC, hblD, and entFM were amplified using PCR. The PCR results were displayed in Table 3. It showed that both B. HLJ1 and B. C1 do not have the enterotoxin genes nheA, nheB, nheC, hblA, hblC, hblD, and entFM, indicating that they are safe for application in aquaculture.

Table 3.
Distribution of virulence genes in B. C1 and B. HLJ1.
3.4. Acid Tolerance and Spore Production of the Candidate Strains
The gastrointestinal tract of aquatic animals is an acid environment, and acid tolerance is also one of the evaluation criteria for probiotics in order to survive and colonize the gastrointestinal tract. The acid tolerance assay revealed that B. C1 and B. HLJ1 were highly tolerant to acid environments (Figure 3A). When B. C1 and B. HLJ1 were treated in PBS from pH 4 to 6 for 2 h, the survival rate reached above 96%. Even after treatment at pH 3 for 2 h, the survival rates of B. C1 and B. HLJ1 exceeded 94% and 92%, respectively. It was consistent with previous study, as Bacillus sp. YB1701 had a survival rate of 89.9% after treatment for 2 h when the environmental pH was 3 [32].

Figure 3.
Acid tolerance (A) and spore production (B) of B. HLJ1 and B. C1.
In aquaculture, probiotics are often added to feeds for use, and high temperatures are often used in feed production to improve palatability and kill pathogens. To prevent inactivation by high temperatures, probiotics must be heat resistant [36]. The tolerance of Bacillus to high temperature is attributed to the formation of endospores, which can resist high temperatures and other adverse environments [7]. With longer incubation time, the spore production rates of B. C1 and B. HLJ1 gradually increased. When the incubation time reached 36 h, the spore production rates of B. C1 and B. HLJ1 reached 96% and 92%, respectively (Figure 3B). The spore production rates of B. C1 and B. HLJ1 were significantly higher than those of B. methylotrophicus (spore production rate 55%) and B. subtilis (spore production rate 80%) reported in the previous study [37,38].
3.5. Extracellular Enzyme Activity and Aggregation Capacity
Extracellular enzyme production is an important feature of good probiotics, which provide beneficial effects to the host in terms of food absorption and improve aquaculture water quality by degrading organic waste, including amylase, protease, and cellulase [39,40]. As seen from Table 4, B. HLJ1 was able to produce three extracellular enzymes, including amylase, protease, and cellulase, and B. C1 could produce protease and cellulase. It has been reported that B. subtilis SK07 and B. amyloliquefaciens SK27 can produce amylase and protease as well as cellulase, and B. licheniformis ABSK55 can produce protease and cellulase. When they were added to water or feed at a concentration of 109 CFU/mL, they could promote the growth of shrimp [41].

Table 4.
Extracellular enzyme production abilities of B. HLJ1 and B. C1.
The auto-aggregation capacity shows a significant correlation with cell adhesions, contributing to the colonization of probiotics in aquaculture animals, and the capacity to co-aggregate with pathogens can help prevent pathogens from invading aquaculture animals [42,43]. After the first 2 h, the auto-aggregation rates of B. HLJ1 and B. C1 were 63.9% and 45.2%, while after 24 h they were 89.8% and 75.3%, respectively (Figure 4A). The auto-aggregation rates of B. HLJ1 and B. C1 were significantly higher than those previously reported for B. tequilensis, B. velezensis, and B. subtilis after the first 2 h (all below 40%), while also having the same efficacy after 24 h [44]. The results indicated that B. HLJ1 and B. C1 had good cell adhesion abilities. The co-aggregation rates of B. HLJ1 and B. C1 with V. parahaemolyticus were 43.4% and 36.7% after the first 2 h, while they were 65.6% and 74.3% at 24 h, respectively (Figure 4B). The results were comparable to those previously reported, such as the co-aggregation rate of B. subtilis with Aeromonas hydrophila being 80% after 24 h [33], indicating the great potential of B. HLJ1 and B. C1 to control V. parahaemolyticus infection in aquaculture animals.

Figure 4.
Aggregation capacity of B. HLJ1 and B. C1. (A) Auto-aggregation rate, (B) co-aggregation rate with V. parahaemolyticus.
3.6. Identification of Anti-V. parahaemolyticus Substance
Bacillus produces a diverse array of over 20 different types of antimicrobial compounds, including antibiotics, bacteriocins, and lipopeptides [45]. Gao et al. [46] reported that B. subtilis H2 produces an anti-Vibrio substance that inhibits the growth of 29 Vibrio strains by disrupting cell membranes and causing cell lysis, structurally identical to amicoumacin A. The HPLC diagram showed the active peaks where the anti-V. parahaemolyticus substances were located (Figure 5A), and the UV (MeOH) spectrum of the anti-V. parahaemolyticus compound displayed bands at 315 nm, 247 nm, and 209 nm. The molecular mass of anti-V. parahaemolyticus compound produced by B. HLJ1 and B. C1 were analyzed using an LC/MS system, and the (M+H)+ ion at m/z 390.1542 Da and 390.1541 Da (Figure 5B). Comparison with previous studies [47,48,49,50,51], B. HLJ1 and B. C1 were found to produce the same anti-V. parahaemolyticus substance, identified as AI-77-F (Figure 5C), which was first isolated and identified from B. subtilis AI-77 and belongs to the amicoumacins [52].

Figure 5.
Identification of anti-V. parahaemolyticus substance secreted by two potential probiotics. (A) HPLC diagram of the anti-V. parahaemolyticus compound from B. HLJ1 and B. C1 (the red arrow indicates the peak where the active compound is located), (B) MS analysis of anti-V. parahaemolyticus compound from B. HLJ1 and B. C1, (C) chemical structure of anti-V. parahaemolyticus compound, which was identified as AI-77-F.
3.7. Inhibitory Activity against Different V. parahaemolyticus
Aquaculture conditions for different products such as shrimp, fish, crab, and oyster have large or great diversity, and contain different V. parahaemolyticus. To effectively control the growth of V. parahaemolyticus in different aquaculture environments, it is necessary to test the inhibitory effect of B. HLJ1 and B. C1 on different sources of V. parahaemolyticus. Inhibitory activities of B. HLJ1 and B. C1 against 11 different V. parahaemolyticus were tested using a double-layer plate method. B. HLJ1 and B. C1 showed inhibitory activity against all V. parahaemolyticus, although there were variations in their inhibitory effects against different V. parahaemolyticus (Table 5). In exception to V. parahaemolyticus ATCC17802 (Figure 6), B. C1 showed high inhibitory activity against V. parahaemolyticus from cuttlefish, mantis shrimp, and scallop and showed moderate inhibitory activity against V. parahaemolyticus from oyster, forktail, hairtail, grass shrimp, haliotis, and crab. B. C1 also showed low inhibitory activity against V. parahaemolyticus from lobster. B. HLJ1 showed moderate inhibitory activity against V. parahaemolyticus from cuttlefish and mantis shrimp and showed low inhibitory activity against V. parahaemolyticus from oyster, forktail, hairtail, grass shrimp, lobster, haliotis, scallop, and crab. The results indicate the potential of B. HLJ1 and B. C1 to control different sources of V. parahaemolyticus.

Table 5.
Inhibitory activity against different V. parahaemolyticus.
Figure 6.
Inhibition zone (mm) by B. C1 and B. HLJ1 against V. parahaemolyticus 17802.
3.8. Anti-V. parahaemolyticus Effect in Simulated Aquaculture Wastewater
In aquaculture, the pathogenic bacteria could cause a disease outbreak when they reach a concentration of approximately 104 CFU/mL [53]. In this study, B. HLJ1 and B. C1 were co-cultured with V. parahaemolyticus (104 CFU/mL) at three initial concentrations in simulated aquaculture wastewater, respectively. When the initial concentration of B. HLJ1 was 1 × 105 CFU/mL, it showed low inhibitory activity against the growth of V. parahaemolyticus. When the initial concentration of B. HLJ1 was 1 × 106 CFU/mL, it could reduce V. parahaemolyticus by more than two orders of magnitude (2.35 lg) at 48 h. When the initial concentration of B. HLJ1 was 1 × 107 CFU/mL, B. HLJ1 reduced V. parahaemolyticus by about three orders of magnitude (2.67 lg) at 12 h, by more than four orders of magnitude (4.45 lg) at 24 h, and completely inhibited V. parahaemolyticus at 48 h (Figure 7A). However, when the initial concentrations of B. C1 were 1 × 105 CFU/mL and 1 × 106 CFU/mL, it showed low inhibitory activity against the growth of V. parahaemolyticus at 12 h and 24 h, and completely inhibited V. parahaemolyticus at 48 h. When the initial concentration of B. C1 was 1 × 107 CFU/mL, B. C1 reduced V. parahaemolyticus by about two orders of magnitude (1.99 lg) at 12 h, by more than four orders of magnitude (4.14 lg) at 24 h, and completely inhibited V. parahaemolyticus at 48 h (Figure 7B). The inhibitory activity against V. parahaemolyticus was influenced by the concentration, and this finding supports previous research that the number of antagonistic bacteria must be higher than the number of pathogens for effective control [54].

Figure 7.
Anti-V. parahaemolyticus effect of two strains in simulated aquaculture wastewater. (A) B. HLJ1, (B) B. C1. The initial concentrations of B. HLJ1 and B. C1 were 105 CFU/mL (Red), 106 CFU/mL (Blue), 107 CFU/mL (Green).
4. Discussion
The long-term use of antibiotics has caused aquaculture to face numerous challenges, including the development of antibiotic-resistant bacteria, drug residues, and environmental contamination [6]. Therefore, finding alternative methods of disease prevention is essential for sustainable aquaculture [55]. According to the research, there is a promising prospect of replacing antibiotics with probiotics in aquaculture [56].
In this study, two probiotics that inhibit V. parahaemolyticus were isolated from aquaculture water (B. C1 and B. HLJ1). B. C1 and B. HLJ1 were identified as B. pumilus and B. subtilis by using the gyrB and pycA sequences. Many studies have reported the inhibitory effect of Bacillus on pathogenic bacteria [7]. The probiotic B. licheniformis exhibits strong inhibitory activity against A. hydrophila and feeding diets supplemented with B. licheniformis (108 CFU/g of feed) improved the immunity of Labeo rohita and its resistance to A. hydrophila [57]. Another study found that B. velezensis had inhibitory effects on V. parahaemolyticus, A. veronii, and Plesiomonas; the inhibition effect increases with the rising concentration of B. velezensis and when the concentration reaches 2.7 × 108 CFU/mL, the inhibition effect is significant [58]. In this study, B. C1 and B. HLJ1 effectively inhibited V. parahaemolyticus at a concentration of 107 CFU/mL. The inhibition activity against V. parahaemolyticus was influenced by the concentration, a finding similar to that previously reported [54].
In aquaculture, probiotics should not carry antibiotic-resistant genes and be non-pathogenic to aquaculture animals [59]. It has been demonstrated that antibiotic-resistant bacteria transfer resistance genes to other bacteria, resulting in the emergence of more and more antibiotic-resistant bacteria [33]. In this study, both B. C1 and B. HLJ1 were sensitive to most of antibiotics recommended by EFSA (FEEDAP 2012). Probiotics cannot contain virulence genes because bacteria carrying virulence genes may cause disease outbreaks in aquaculture animals [30]. The results of the virulence gene detection experiment revealed that B. C1 and B. HLJ1 do not have the enterotoxin genes (nheA, nheB, nheC, hblA, hblC, hblD, and entFM). The safety shown by B. HLJ1 and B. C1 makes them prospective for use as probiotics in aquaculture.
Heating is frequently used in aquaculture feed production to improve palatability and kill pathogens [36]. Therefore, probiotics must be heat-resistant. The heat resistance of Bacillus is mainly due to its ability to produce endospores, so the heat resistance of Bacillus is generally assessed by evaluating its ability to produce spores [7]. In this experiment, both B. C1 and B. HLJ1 had high spore production rates. When incubated in LB medium for 36 h, the spore production rates of B. C1 and B. HLJ1 reached 96% and 92%, respectively. Probiotics should be acid-tolerant in order to colonize the gastrointestinal tract of aquatic animals. Even after 2 h of treatment at pH 3, the survival rates of B. C1 and B. HLJ1 exceeded 94% and 92%, respectively. The results of the experiments revealed that B. C1 and B. HLJ1 have a high tolerance to acid environments.
The production of extracellular enzymes is one of the criteria for assessing probiotics, which promote the growth and development of aquatic animals as well as improve the quality of aquaculture water [39,40]. It has been reported that B. methylotrophicus can produce amylase, lipase, and protease, promoting the growth of fish [60]. In this study, B. HLJ1 can produce protease, cellulase, and amylase, and B. C1 can produce protease and cellulase. The results suggest that both strains have probiotic potential. Canzi et al. [42] found that co-aggregation of probiotics and pathogens could reduce pathogens attachment in the digestive tract of aquaculture animals. In addition, there was a strong correlation between the auto-aggregation ability of probiotics and their adhesion to aquaculture animals [43]. In this study, B. C1 and B. HLJ1 showed good auto-aggregation capacity and co-aggregation capacity with V. parahaemolyticus. This finding is consistent with a previous study showing that Bacillus has the ability to auto-aggregate and co-aggregate with A. hydrophila and E. faecalis [61].
One of the main mechanisms by which probiotics inhibit pathogens is through the secretion of antibacterial substances [62]. Based on previous studies [47,48,49,50,51] and MS analysis, the anti-V. parahaemolyticus substances produced by B. C1 and B. HLJ1 were identical to AI-77-F. The AI-77 series compounds, first isolated and identified from B. subtilis AI-77 by Shimojima et al. [52], belong to the amicoumacins. Huang et al. [49] isolated AI-77-F from Alternaria tenuis Sg17-1 and investigated its inhibitory effect on human malignant tumor A375-S2 and Hela cells, but the effect was very weak. Shi et al. [51] isolated AI-77-F from B. subtilis subsp. Inaquosorum and found that it had potential inhibitory activity against quorum sensing (QS) and could be used in the development of a novel anti-microbial agent to treat pathogenic infections. In this study, it is the first report that AI-77-F has inhibitory activity against V. parahaemolyticus.
Compared to laboratory conditions, aquaculture environments are more complex, nutrient-poor, and contain different V. parahaemolyticus. Both B. C1 and B. HLJ1 showed inhibitory activity against 11 different V. parahaemolyticus and could effectively control the growth of V. parahaemolyticus in simulated aquaculture wastewater when the concentration reached 1 × 107 CFU/mL. The results showed their great potential as probiotics for application in different aquaculture environments to control V. parahaemolyticus.
In conclusion, B. HLJ1 and B. C1 have inhibitory activity against V. parahaemolyticus, and the most effective dose of both probiotics B. C1 and B. HLJ1 to control V. parahaemolyticus was 107 CFU/mL. Based on the most effective doses of B. C1 and B. HLJ1 against V. parahaemolyticus and the commercial market price in China, the cost of using B. C1 and B. HLJ1 for effective control of V. parahaemolyticus in aquaculture can be estimated to be about USD 0.0241/m3 [63]. The safety tests indicated that they were safe for application in aquaculture. B. HLJ1 and B. C1 can also tolerate acid environments, produce spores, secrete extracellular enzymes, and co-aggregate as well as auto-aggregate with V. parahaemolyticus. As a result, there is great potential for using B. HLJ1 and B. C1 as aquaculture probiotics.
Author Contributions
Conceptualization, N.J. and J.W.; methodology, N.J.; software, N.J.; validation, N.J., B.H. and Y.L.; formal analysis, N.J.; investigation, N.J. and K.L.; resources, N.J. and J.W.; data curation, N.J.; writing—original draft preparation, N.J.; writing—review and editing, N.J., B.H., Y.L., H.F. and J.W.; visualization, N.J.; supervision, J.W.; project administration, J.W.; funding acquisition, J.W. All authors have read and agreed to the published version of the manuscript.
Funding
This research received no external funding.
Data Availability Statement
The raw data supporting the conclusion of this article will be made available by the authors, without undue reservation.
Conflicts of Interest
The authors claim no conflict of interest.
References
- Nayak, S.K. Multifaceted applications of probiotic Bacillus species in aquaculture with special reference to Bacillus Subtilis. Rev. Aquac. 2021, 13, 862–906. [Google Scholar] [CrossRef]
- Hoseinifar, S.H.; Sun, Y.Z.; Wang, A.R.; Zhou, Z.G. Probiotics as Means of Diseases Control in Aquaculture, a Review of Current Knowledge and Future Perspectives. Front. Microbiol. 2018, 9, 18. [Google Scholar] [CrossRef]
- Chau, K.M.; Van, T.T.H.; Quyen, D.V.; Le, H.D.; Phan, T.H.T.; Ngo, N.D.T.; Vo, T.D.T.; Dinh, T.T.; Le, H.T.; Khanh, H.H.N. Molecular Identification and Characterization of Probiotic Bacillus Species with the Ability to Control Vibrio spp. in Wild Fish Intestines and Sponges from the Vietnam Sea. Microorganisms 2021, 9, 16. [Google Scholar] [CrossRef]
- Nguyen, T.V.; Alfaro, A.; Arroyo, B.B.; Leon, J.A.R.; Sonnenholzner, S. Metabolic responses of penaeid shrimp to acute hepatopancreatic necrosis disease caused by Vibrio parahaemolyticus. Aquaculture 2021, 533, 8. [Google Scholar] [CrossRef]
- Shinn, A.; Pratoomyot, J.; Griffiths, D.; Trọng, T.; Nguyen, V.; Jiravanichpaisal, P.; Briggs, M. Asian Shrimp Production and the Economic Costs of Disease. Asian Fish. Sci. 2018, 31S, 29–58. [Google Scholar] [CrossRef]
- Chen, J.M.; Sun, R.X.; Pan, C.G.; Sun, Y.; Mai, B.X.; Li, Q.X. Antibiotics and Food Safety in Aquaculture. J. Agric. Food Chem. 2020, 68, 11908–11919. [Google Scholar] [CrossRef]
- Kuebutornye, F.K.A.; Abarike, E.D.; Lu, Y. A review on the application of Bacillus as probiotics in aquaculture. Fish Shellfish Immunol. 2019, 87, 820–828. [Google Scholar] [CrossRef]
- Amin Jahari, M.; Shuhaimi, M.; Akhmal, M.; Roslan, H.; Lamasudin, D.U.; Manap, Y.; Amin, M. Encapsulation of Lactobacillus plantarum with Mannan and Sodium Alginate Improves its Cell Production. J. Biochem. Microbiol. Biotechnol. 2019, 7, 17–22. [Google Scholar] [CrossRef]
- Banerjee, G.; Ray, A.K. The advancement of probiotics research and its application in fish farming industries. Res. Vet. Sci. 2017, 115, 66–77. [Google Scholar] [CrossRef]
- Chomwong, S.; Charoensapsri, W.; Amparyup, P.; Tassanakajon, A. Two host gut-derived lactic acid bacteria activate the proPO system and increase resistance to an AHPND-causing strain of Vibrio parahaemolyticus in the shrimp Litopenaeus vannarnei. Dev. Comp. Immunol. 2018, 89, 54–65. [Google Scholar] [CrossRef]
- Xi, D.Y.; Liu, C.C.; Su, Y.C. Effects of green tea extract on reducing Vibrio parahaemolyticus and increasing shelf life of oyster meats. Food Control 2012, 25, 368–373. [Google Scholar] [CrossRef]
- Kewcharoen, W.; Srisapoome, P. Probiotic effects of Bacillus spp. from Pacific white shrimp (Litopenaeus vannamei) on water quality and shrimp growth, immune responses, and resistance to Vibrio parahaemolyticus (AHPND strains). Fish Shellfish Immunol. 2019, 94, 175–189. [Google Scholar] [CrossRef] [PubMed]
- Amoah, K.; Huang, Q.C.; Tan, B.P.; Zhang, S.; Chi, S.Y.; Yang, Q.H.; Liu, H.Y.; Dong, X.H. Dietary supplementation of probiotic Bacillus coagulans ATCC 7050, improves the growth performance, intestinal morphology, microflora, immune response, and disease confrontation of Pacific white shrimp, Litopenaeus vannamei. Fish Shellfish Immunol. 2019, 87, 796–808. [Google Scholar] [CrossRef] [PubMed]
- Amoah, K.; Dong, X.H.; Tan, B.P.; Zhang, S.; Chi, S.Y.; Yang, Q.H.; Liu, H.Y.; Yang, Y.Z.; Zhang, H.T. Administration of probiotic Bacillus licheniformis induces growth, immune and antioxidant enzyme activities, gut microbiota assembly and resistance to Vibrio parahaemolyticus in Litopenaeus vannamei. Aquac. Nutr. 2020, 26, 1604–1622. [Google Scholar] [CrossRef]
- Won, S.; Hamidoghli, A.; Choi, W.; Bae, J.H.; Jang, W.J.; Lee, S.; Bai, S.C. Evaluation of Potential Probiotics Bacillus subtilis WB60, Pediococcus pentosaceus, and Lactococcus lactis on Growth Performance, Immune Response, Gut Histology and Immune-Related Genes in Whiteleg Shrimp, Litopenaeus vannamei. Microorganisms 2020, 8, 15. [Google Scholar] [CrossRef]
- Ruiz-Moyanoa, S.; dos Santos, M.; Galvan, A.I.; Merchan, A.V.; Gonzalez, E.; Cordoba, M.D.; Benito, M.J. Screening of autochthonous lactic acid bacteria strains from artisanal soft cheese: Probiotic characteristics and prebiotic metabolism. Lwt Food Sci. Technol. 2019, 114, 7. [Google Scholar] [CrossRef]
- Priyodip, P.; Balaji, S. A Preliminary Study on Probiotic Characteristics of Sporosarcina spp. for Poultry Applications. Curr. Microbiol. 2019, 76, 448–461. [Google Scholar] [CrossRef]
- Kavitha, M.; Raja, M.; Perumal, P. Evaluation of probiotic potential of Bacillus spp. isolated from the digestive tract of freshwater fish Labeo calbasu (Hamilton, 1822). Aquac. Rep. 2018, 11, 59–69. [Google Scholar] [CrossRef]
- Ceccarelli, D.; Hasan, N.A.; Huq, A.; Colwell, R.R. Distribution and dynamics of epidemic and pandemic Vibrio parahaemolyticus virulence factors. Front. Cell. Infect. Microbiol. 2013, 3, 9. [Google Scholar] [CrossRef]
- Liang, X.R.; Wang, Y.H.; Hong, B.; Li, Y.M.; Ma, Y.; Wang, J.F. Isolation and Characterization of a Lytic Vibrio parahaemolyticus Phage vB_VpaP_GHSM17 from Sewage Samples. Viruses 2022, 14, 15. [Google Scholar] [CrossRef]
- Schillinger, U.; Lucke, F.K. Antibacterial activity of Lactobacillus sake isolated from meat. Appl. Environ. Microbiol. 1989, 55, 1901–1906. [Google Scholar] [CrossRef] [PubMed]
- Goulden, E.F.; Hall, M.R.; Pereg, L.L.; Høj, L. Identification of an Antagonistic Probiotic Combination Protecting Ornate Spiny Lobster (Panulirus ornatus) Larvae against Vibrio owensii Infection. PLoS ONE 2012, 7, e39667. [Google Scholar] [CrossRef]
- Wattiau, P.; Renard, M.E.; Ledent, P.; Debois, V.; Blackman, G.; Agathos, S.N. A PCR test to identify Bacillus subtilis and closely related species and its application to the monitoring of wastewater biotreatment. Appl. Microbiol. Biotechnol. 2001, 56, 816–819. [Google Scholar] [CrossRef]
- Dong, Q.; Liu, Q.; Goodwin, P.H.; Deng, X.; Xu, W.; Xia, M.; Zhang, J.; Sun, R.; Wu, C.; Wang, Q.; et al. Isolation and Genome-Based Characterization of Biocontrol Potential of Bacillus siamensis YB-1631 against Wheat Crown Rot Caused by Fusarium pseudograminearum. J. Fungi 2023, 9, 547. [Google Scholar] [CrossRef] [PubMed]
- Flores, A.; Valencia-Marin, M.F.; Chavez-Avila, S.; Ramirez-Diaz, M.I.; de Los Santos-Villalobos, S.; Meza-Carmen, V.; Orozco-Mosqueda, M.D.C.; Santoyo, G. Genome mining, phylogenetic, and functional analysis of arsenic (As) resistance operons in Bacillus strains, isolated from As-rich hot spring microbial mats. Microbiol. Res. 2022, 264, 127158. [Google Scholar] [CrossRef] [PubMed]
- Wang, W.Y.; Kong, W.L.; Liao, Y.C.Z.; Zhu, L.H. Identification of Bacillus velezensis SBB and Its Antifungal Effects against Verticillium dahliae. J. Fungi 2022, 8, 18. [Google Scholar] [CrossRef]
- Lee, G.; Heo, S.; Kim, T.; Na, H.E.; Park, J.; Lee, E.; Lee, J.H.; Jeong, D.W. Discrimination of Bacillus subtilis from Other Bacillus Species Using Specific Oligonucleotide Primers for the Pyruvate Carboxylase and Shikimate Dehydrogenase Genes. J. Microbiol. Biotechnol. 2022, 32, 1011–1016. [Google Scholar] [CrossRef]
- Mazlan, S.; Jaafar, M.N.; Wahab, A.; Sulaiman, Z.; Rajandas, H.; Zulperi, D. Molecular characterization and phylogenetic analysis of Bacillus pumilus causing trunk bulges of RRIM 3001 superclone rubber tree in Malaysia. Eur. J. Plant Pathol. 2021, 159, 825–838. [Google Scholar] [CrossRef]
- Kabore, D.; Gagnon, M.; Roy, D.; Sawadogo-Lingani, H.; Diawara, B.; LaPointe, G. Rapid screening of starter cultures for maari based on antifungal properties. Microbiol. Res. 2018, 207, 66–74. [Google Scholar] [CrossRef]
- Anokyewaa, M.A.; Amoah, K.; Li, Y.; Lu, Y.S.; Kuebutornye, F.K.A.; Asiedu, B.; Seidu, I. Prevalence of virulence genes and antibiotic susceptibility of Bacillus used in commercial aquaculture probiotics in China. Aquac. Rep. 2021, 21, 8. [Google Scholar] [CrossRef]
- Aarti, C.; Khusro, A.; Varghese, R.; Arasu, M.V.; Agastian, P.; Al-Dhabi, N.A.; Ilavenil, S.; Choi, K.C. In vitro studies on probiotic and antioxidant properties of Lactobacillus brevis strain LAP2 isolated from Hentak, a fermented fish product of North-East India. Lwt-Food Sci. Technol. 2017, 86, 438–446. [Google Scholar] [CrossRef]
- Zhou, S.X.; Xia, Y.; Zhu, C.M.; Chu, W.H. Isolation of Marine Bacillus sp with Antagonistic and Organic-Substances-Degrading Activities and Its Potential Application as a Fish Probiotic. Mar. Drugs 2018, 16, 12. [Google Scholar] [CrossRef] [PubMed]
- Mustafa, S.; Abbasiliasi, S.; Zulkifly, S.; Sam-on, M.F.S.; Yusof, M.T.; Hashim, A.M.; Jahari, M.A.; Roslan, M.A.H. Evaluation of three Bacillus spp. isolated from the gut of giant freshwater prawn as potential probiotics against pathogens causing Vibriosis and Aeromonosis. Microb. Pathog. 2022, 164, 12. [Google Scholar] [CrossRef]
- Zhang, M.Y.; Pan, L.Q.; Su, C.; Liu, L.P.; Dou, L. Simultaneous aerobic removal of phosphorus and nitrogen by a novel salt-tolerant phosphate-accumulating organism and the application potential in treatment of domestic sewage and aquaculture sewage. Sci. Total Environ. 2021, 758, 12. [Google Scholar] [CrossRef] [PubMed]
- Bernhard, K.; Schrempf, H.; Goebel, W. Bacteriocin and antibiotic resistance plasmids in Bacillus cereus and Bacillus subtilis. J. Bacteriol. 1978, 133, 897–903. [Google Scholar] [CrossRef] [PubMed]
- Guo, X.; Chen, D.D.; Peng, K.S.; Cui, Z.W.; Zhang, X.J.; Li, S.; Zhang, Y.A. Identification and characterization of Bacillus subtilis from grass carp (Ctenopharynodon idellus) for use as probiotic additives in aquatic feed. Fish Shellfish. Immunol. 2016, 52, 74–84. [Google Scholar] [CrossRef]
- Zhang, Y.; Wu, Z.; Yu, M.; Zhang, D.; Wang, Q.; Lin, L.; Wang, G.; Elsadek, M.M.; Yao, Q.; Chen, Y.; et al. Evaluating the probiotic potential and adhesion characteristics of Bacillus spp. isolated from the intestine of Rhynchocypris lagowskii Dybowski. Aquac. Int. 2022, 30, 747–772. [Google Scholar] [CrossRef]
- Wang, J.J.; Wu, Z.C.; Wang, S.; Wang, X.; Zhang, D.M.; Wang, Q.J.; Lin, L.L.; Wang, G.Q.; Guo, Z.X.; Chen, Y.K. Inhibitory effect of probiotic Bacillus spp. isolated from the digestive tract of Rhynchocypris Lagowskii on the adhesion of common pathogenic bacteria in the intestinal model. Microb. Pathog. 2022, 169, 11. [Google Scholar] [CrossRef]
- Bairagi, A.; Ghosh, K.S.; Sen, S.K.; Ray, A.K. Evaluation of the nutritive value of Leucaena leucocephala leaf meal, inoculated with fish intestinal bacteria Bacillus subtilis and Bacillus circulans in formulated diets for rohu, Labeo rohita (Hamilton) fingerlings. Aquac. Res. 2004, 35, 436–446. [Google Scholar] [CrossRef]
- Thurlow, C.M.; Williams, M.A.; Carrias, A.; Ran, C.; Newman, M.; Tweedie, J.; Allison, E.; Jescovitch, L.N.; Wilson, A.E.; Terhune, J.S.; et al. Bacillus velezensis AP193 exerts probiotic effects in channel catfish (Ictalurus punctatus) and reduces aquaculture pond eutrophication. Aquaculture 2019, 503, 347–356. [Google Scholar] [CrossRef]
- Fernandes, S.; Kerkar, S.; Leitao, J.; Mishra, A. Probiotic Role of Salt Pan Bacteria in Enhancing the Growth of Whiteleg Shrimp, Litopenaeus vannamei. Probiotics Antimicrob. Proteins 2019, 11, 1309–1323. [Google Scholar] [CrossRef]
- Canzi, E.; Guglielmetti, S.; Mora, D.; Tamagnini, I.; Parini, C. Conditions affecting cell surface properties of human intestinal bifidobacteria. Antonie Van Leeuwenhoek Int. J. Gen. Mol. Microbiol. 2005, 88, 207–219. [Google Scholar] [CrossRef] [PubMed]
- Kos, B.; Suskovic, J.; Vukovic, S.; Simpraga, M.; Frece, J.; Matosic, S. Adhesion and aggregation ability of probiotic strain Lactobacillus acidophilus M92. J. Appl. Microbiol. 2003, 94, 981–987. [Google Scholar] [CrossRef]
- Amoah, K.; Dong, X.H.; Tan, B.P.; Zhang, S.; Kuebutornye, F.K.A.; Chi, S.Y.; Yang, Q.H.; Liu, H.Y.; Zhang, H.T.; Yang, Y.Z. In vitro Assessment of the Safety and Potential Probiotic Characteristics of Three Bacillus Strains Isolated from the Intestine of Hybrid Grouper (Epinephelus fuscoguttatus female x Epinephelus lanceolatus male). Front. Vet. Sci. 2021, 8, 16. [Google Scholar] [CrossRef] [PubMed]
- Knipe, H.; Temperton, B.; Lange, A.; Bass, D.; Tyler, C.R. Probiotics and competitive exclusion of pathogens in shrimp aquaculture. Rev. Aquac. 2021, 13, 324–352. [Google Scholar] [CrossRef]
- Gao, X.Y.; Liu, Y.; Miao, L.L.; Li, E.W.; Hou, T.T.; Liu, Z.P. Mechanism of anti-Vibrio activity of marine probiotic strain Bacillus pumilus H2, and characterization of the active substance. AMB Express 2017, 7, 10. [Google Scholar] [CrossRef]
- Itoh, J.; Omoto, S.; Shomura, T.; Nishizawa, N.; Miyado, S.; Yuda, Y.; Shibata, U.; Inouye, S. Amicoumacin-A, a new antibiotic with strong anti-inflammatory and antiulcer activity. J. Antibiot. 1981, 34, 611–613. [Google Scholar] [CrossRef]
- Shimojima, Y.; Hayashi, H.; Ooka, T.; Shibukawa, M.; Iitaka, Y. (Studies on AI-77s, microbial products with pharmacological activity) structures and the chemical nature of AI-77s. Tetrahedron Lett. 1982, 23, 5435–5438. [Google Scholar] [CrossRef]
- Huang, Y.F.; Li, L.H.; Tian, L.; Qiao, L.; Hua, H.M.; Pei, Y.H. Sg17-1-4, a novel isocoumarin from a marine fungus Alternaria tenuis Sg17-1. J. Antibiot. 2006, 59, 355–357. [Google Scholar] [CrossRef]
- Boya, C.A.; Herrera, L.; Guzman, H.M.; Gutierrez, M. Antiplasmodial activity of bacilosarcin A isolated from the octocoral-associated bacterium Bacillus sp. collected in Panama. J. Pharm. Bioallied Sci. 2012, 4, 66–69. [Google Scholar] [CrossRef]
- Shi, W.P.; Zeng, H.; Wan, C.X.; Zhou, Z.B. Amicoumacins from a desert bacterium: Quorum sensing inhibitor against Chromobacterium violaceum. Nat. Prod. Res. 2021, 35, 5508–5512. [Google Scholar] [CrossRef]
- Shimojima, Y.; Hayashi, H.; Ooka, T.; Shibukawa, M.; Iitaka, Y. Studies on AI-77s, microbial products with gastroprotective activity. Structures and the chemical nature of AI-77s. Tetrahedron 1984, 40, 2519–2527. [Google Scholar] [CrossRef]
- Shi, L.Y.; Liang, S.; Luo, X.; Ke, C.H.; Zhao, J. Microbial community of Pacific abalone (Haliotis discus hannai) juveniles during a disease outbreak in South China. Aquac. Res. 2017, 48, 1080–1088. [Google Scholar] [CrossRef]
- Jayaprakash, N.S.; Pai, S.S.; Anas, A.; Preetha, R.; Philip, R.; Singh, I.S.B. A marine bacterium, Micrococcus MCCB 104, antagonistic to vibrios in prawn larval rearing systems. Dis. Aquat. Org. 2005, 68, 39–45. [Google Scholar] [CrossRef] [PubMed]
- Yilmaz, S.; Yilmaz, E.; Dawood, M.A.O.; Ringo, E.; Ahmadifar, E.; Abdel-Latif, H.M.R. Probiotics, prebiotics, and synbiotics used to control vibriosis in fish: A review. Aquaculture 2022, 547, 15. [Google Scholar] [CrossRef]
- Bentzon-Tilia, M.; Sonnenschein, E.C.; Gram, L. Monitoring and managing microbes in aquaculture—Towards a sustainable industry. Microb. Biotechnol. 2016, 9, 576–584. [Google Scholar] [CrossRef] [PubMed]
- Ramesh, D.; Vinothkanna, A.; Rai, A.K.; Vignesh, V.S. Isolation of potential probiotic Bacillus spp. and assessment of their subcellular components to induce immune responses in Labeo rohita against Aeromonas hydrophila. Fish Shellfish Immunol. 2015, 45, 268–276. [Google Scholar] [CrossRef] [PubMed]
- Li, X.X.; Gao, X.J.; Zhang, S.M.; Jiang, Z.Y.; Yang, H.; Liu, X.D.; Jiang, Q.; Zhang, X.J. Characterization of a Bacillus velezensis with antibacterial activity and inhibitory effect on common aquatic pathogens. Aquaculture 2020, 523, 9. [Google Scholar] [CrossRef]
- Verschuere, L.; Rombaut, G.; Sorgeloos, P.; Verstraete, W. Probiotic bacteria as biological control agents in aquaculture. Microbiol. Mol. Biol. Rev. 2000, 64, 655. [Google Scholar] [CrossRef]
- Mukherjee, A.; Ghosh, K. Antagonism against fish pathogens by cellular components and verification of probiotic properties in autochthonous bacteria isolated from the gut of an Indian major carp, Catla catla (Hamilton). Aquac. Res. 2016, 47, 2243–2255. [Google Scholar] [CrossRef]
- Samson, J.S.; Choresca, C.H.; Quiazon, K.M.A. Selection and screening of bacteria from African nightcrawler, Eudrilus eugeniae (Kinberg, 1867) as potential probiotics in aquaculture. World J. Microbiol. Biotechnol. 2020, 36, 16. [Google Scholar] [CrossRef] [PubMed]
- Bermudez-Brito, M.; Plaza-Diaz, J.; Munoz-Quezada, S.; Gomez-Llorente, C.; Gil, A. Probiotic Mechanisms of Action. Ann. Nutr. Metab. 2012, 61, 160–174. [Google Scholar] [CrossRef] [PubMed]
- Zhao, S.M.; Deng, L.; Hu, N.; Zhao, B.; Liang, Y.X. Cost-effective production of Bacillus licheniformis using simple netting bag solid bioreactor. World J. Microbiol. Biotechnol. 2008, 24, 2859–2863. [Google Scholar] [CrossRef]
Disclaimer/Publisher’s Note: The statements, opinions and data contained in all publications are solely those of the individual author(s) and contributor(s) and not of MDPI and/or the editor(s). MDPI and/or the editor(s) disclaim responsibility for any injury to people or property resulting from any ideas, methods, instructions or products referred to in the content. |
© 2023 by the authors. Licensee MDPI, Basel, Switzerland. This article is an open access article distributed under the terms and conditions of the Creative Commons Attribution (CC BY) license (https://creativecommons.org/licenses/by/4.0/).







